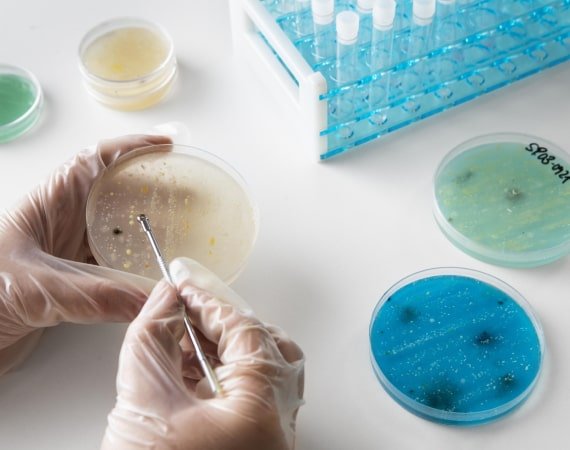

Quartz Silica
Quartz Silica, often simply referred to as quartz, is a versatile and abundant mineral found in the Earth's crust. Composed of silicon and oxygen atoms in a continuous framework of SiO2, quartz is a fundamental component of various rocks, making up a significant portion of the Earth's continental crust.
Properties of Quartz Silica
- Crystal Structure:
Quartz exhibits a unique crystal structure, forming hexagonal prisms terminated with six-sided pyramids. This distinctive structure gives quartz its remarkable clarity and durability.
- Hardness:
- Transparency:
One of the defining features of quartz is its hardness. Ranking 7 on the Mohs scale, quartz is harder than many common minerals, making it resistant to scratches and abrasions.
While quartz is commonly transparent, it can also appear in various colors due to impurities. Clear quartz is prized for its purity, but variations like amethyst, citrine, and rose quartz showcase the mineral's diverse aesthetic appeal.
Industrial Applications
Quartz Silica's exceptional properties make it an indispensable material in various industries:
- Glass Manufacturing:
- Electronics:
- Construction:
- Oil and Gas Exploration:
Quartz is a key ingredient in glass production. Its high melting point and low thermal expansion contribute to the creation of durable and heat-resistant glass products.
The semiconductor industry relies heavily on high-purity quartz for the production of silicon wafers. The unique electrical properties of quartz make it an essential component in electronic devices.
In the construction sector, quartz is used in the production of concrete and other building materials. Its hardness and resistance to weathering enhance the durability of structures.
Quartz is crucial in the extraction of oil and gas, where it is used as proppants in hydraulic fracturing processes to maintain fractures in the rock formation.
Environmental Considerations
Despite its widespread use, the extraction and processing of quartz can have environmental implications. Sustainable mining practices and advancements in recycling technologies are crucial for minimizing the ecological impact associated with quartz extraction.
